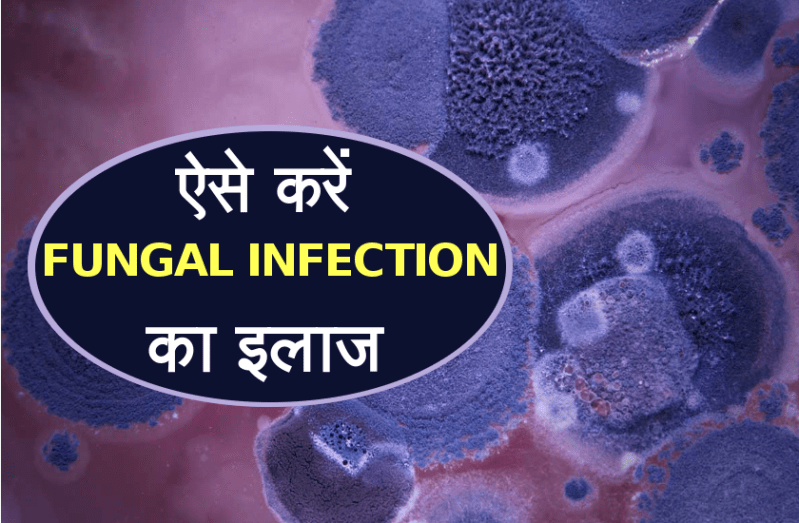
fungal infection

fungal infection
भोपालः मध्य प्रदेश समेत देशभर में सक्रीय हुए मानसून के बाद बारिश का सिलसिला जारी है। प्रदेश में अब तक औसत से 20 फीसदी बारिश दर्ज की जा चुकी है, जिसके चलते हमारी लाइफ लाइन माने जाने वाले पानी की साल भर के लिए लगभग पूर्ति हो चुकी है। जहां एक तरफ बारिश का सीज़न अपने आप में एक सुहाना मौसम लेकर आता है, वहीं कई लोगों को बारिश के कारण होने वाली नमी से फंगल इंफेक्शन की परेशानी भी हो जाती है। ये फंगल इंफेक्शन शरीर के किसी भी हिस्से पर हो सकता है, जिसकी पीड़ा से व्यक्ति को खासा परेशानी होती है। फंगस पैदा करने वाले बैक्टीरिया आमतौर पर मानसून में तेजी से फैलते हैं। जिससे लोगों को सर में डैंड्रफ, खुजली और एक्जीमा हो जाती है। लेकिन क्या आपको पता है कि, घर में मौजूद चीजों से ही हम कारगर तरीके से इस समस्या से निजात पा सकते हैं। आइए जानते हैं इस समस्या से निजात पाने का कारगर तरीका।
इन चीजों से करें फंगल इंफेक्शन का इलाज
एलोवेरा को संजीवनी बूटी कहना गलत नहीं होगा। क्या आपको पता है कि सिर या शरीर के किसी भी हिस्से में होने वाले इंफेक्शन को दूर करने में एलोवेरा जेल काफी कारगर है। यह आपको जलन, खुजली और रैशेज से राहत दिलाने में मददगार है। सर में इंफेक्शन होने पर बालों की जड़ों में एलोवेरा जेल 30 मिनट तक लगाकर छोड़ दें। यहीं प्रक्रिया शरीर के अन्य अंगों पर भी लागू कर सकते हैं। जल्दी ही आपको इस परेशानी से निजात मिल जाएगी।
टी ट्री ऑयल फंगल इंफेक्शन की समस्या को कुछ समय में ही दूर कर देता है। ट्री टी ऑयल को ऑलिव और बादाम के तेल के साथ मिलाकर इंफेक्शन वाली जगह पर लगाने से आप इंफेक्शन की समस्या से निजात पा सकते हैं।
बारिश के मौसम में होने वाला फंगल इंफेक्शन नीम की पत्तियों से भी दूर किया जा सकता है। इसके लिए घर में नीम की पत्तियों का पेस्ट बना लें और उसमें थोडा सा नींबू का रस और थोड़ी हल्दी मिला लें। इस पेस्ट को बालों की जड़ो में 30 मिनट तक लगाकर छोड़ दें। कुछ ही दिनों में आपको फंगल इंफ्केशन से निजात मिलेगी।
-दही
अगर आप या आपका कोई परिचित फंगल इंफेक्शन का दंश झेल रहा है तो उसे रोकने के लिए दही खासा मददगार हो सकता है। दही में मौजूद प्रोबायोटिक्स लैक्टिक एसिड बनाता है, जो फंगल इंफेक्शन की रोकथाम में मददगार होता है।
एक चम्मच हल्दी आपको कई तरह के त्वचा रोगों से निजात दिला सकती है। अगर आप हल्दी में शहद मिलाकर पेस्ट बनाकर इंफेक्शन वाली जगह पर लगाएं तो जल्दी ही आपको इससे मुक्ति मिल सकती है।
Published on:
28 Aug 2019 04:17 pm
